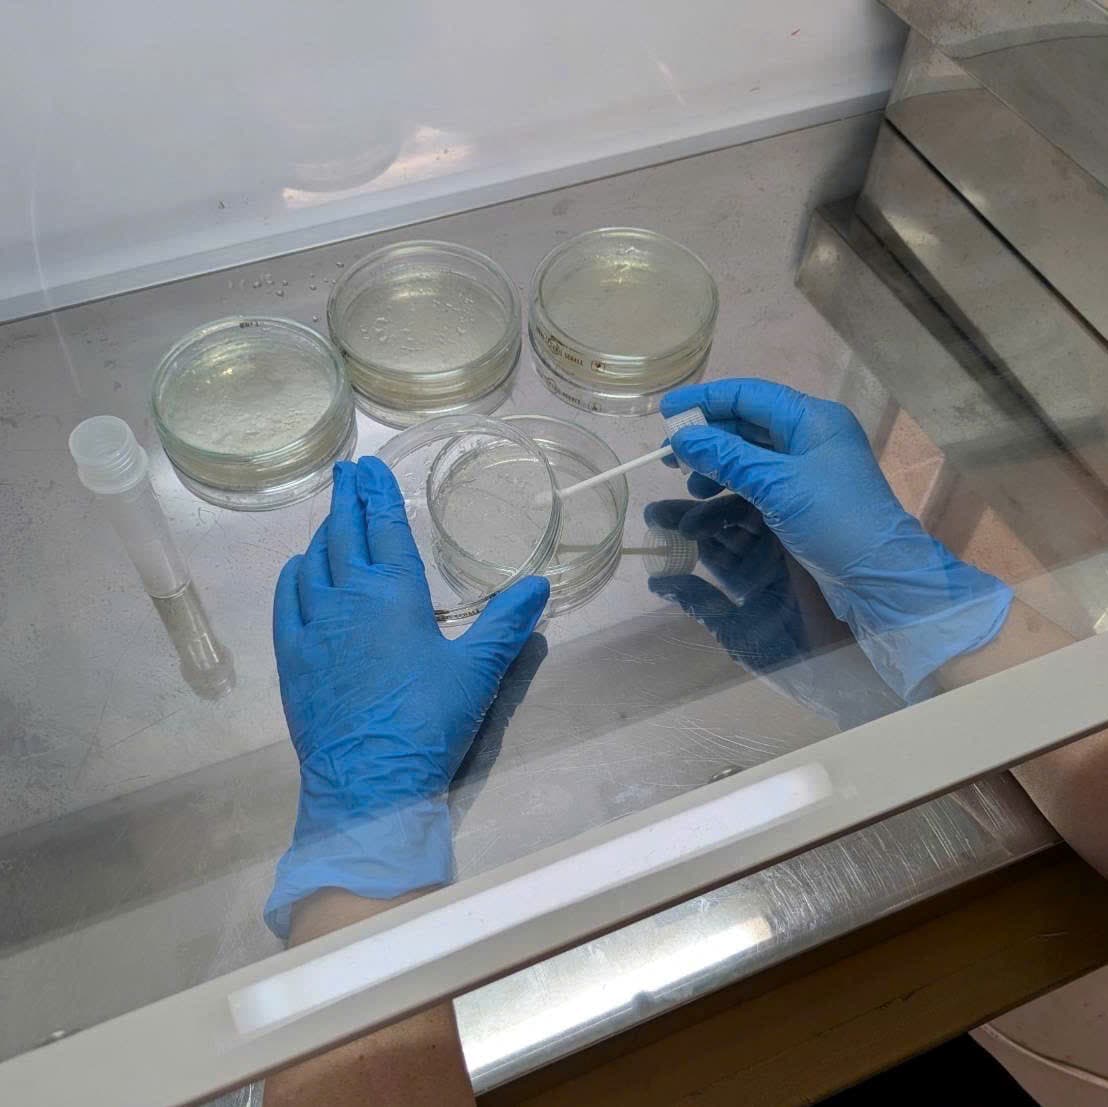

Dự án
Hình Ảnh Hoạt Động
Chúng tôi tự hào phục vụ các doanh nghiệp hàng đầu và thực hiện những dự án kết nối thành công giữa Nhật Bản và Việt Nam.
Hoạt động & Sự kiện của Sovaen

Giải Futsal giao lưu Nhật - Việt lần thứ nhất

Cảnh cảng tại TP.HCM

Gặp gỡ giám đốc nhà cung cấp trong nước Nhật Bản

Quá trình xếp hàng tại công ty International Express Seoul

Công việc đóng container tại kho Kansai

Thịt bò Wagyu từ kênh nhập hàng độc quyền

Đồ thủ công Việt Nam (sản phẩm tre)

Kho của đối tác International Express Hàn Quốc

Dây chuyền sản xuất PAVICO VN
Kiểm tra sản phẩm trong nước Nhật Bản

Sân bay quốc tế Nội Bài

Khu vực trung tâm Hà Nội

Xuất khẩu đồ uống

SAGAWA VIETNAM tại TP.HCM

Khách sạn hợp tác tại Đà Nẵng - EVERLAND HOTEL

Hồ bơi sân thượng EVERLAND HOTEL

Tiệc thân mật tại Đà Nẵng

Sản phẩm bán chạy tại Việt Nam của Minami Healthy Foods

Trụ sở chính Minami Healthy Foods

